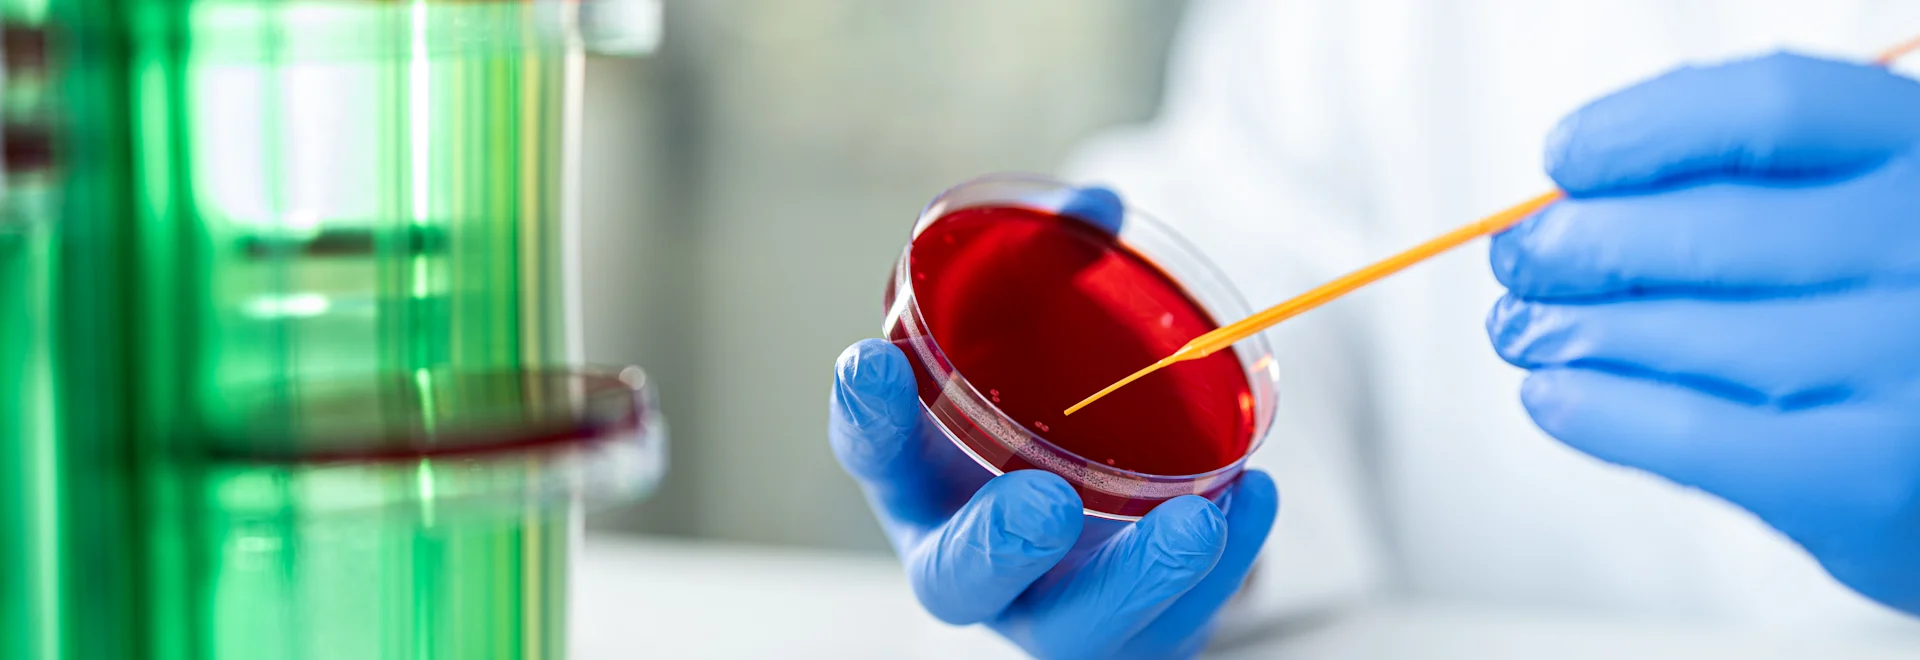

Microbiology
The core areas
Viruses, bacteria, parasites—there are many organisms that cannot be seen with the naked eye but still have significant impacts on the health of humans and animals. They either cause diseases or are beneficial to health, such as the microbiome in the gut.
This is precisely why microbiology is important in fields such as; medicine, biosciences, pharmaceuticals and the food industry.
Microbiology can be divided into two core areas: pure and applied microbiology. Pure microbiology focuses on the study of various microorganisms, while applied microbiology examines the interactions of microorganisms with the environment or other living organisms, and potentially utilises them. In both core areas, an adequate access to various microorganisms is fundamental.
We provide you with high-quality tools for both core areas - for all tasks from sample collection to cultivation and analysis. Our solutions are based on our extensive experience in medicine and research and fulfil the highest demands in terms of quality, purity and convenience. Discover our extensive range and benefit from our expertise in the field of microbiology.

Three Essential Steps for Research, Medicine, and Industry
Regardless of the field in which microbiology is applied, working with microorganisms typically involves three essential steps: sampling, cultivation, and analysis.
Sampling
Before sampling, it is essential to answer the following questions: What are the microorganisms needed for? What is to be analysed or researched? For instance, is the goal to find the ideal therapy for an infection in a human or animal? Is it necessary to prove the absence of certain microorganisms—such as in the food industry? Or is it important to specifically look for certain organisms because they could be crucial for the next successful drug, the so-called blockbuster, in the pharmaceutical industry?

Sampling: The Choice Depends on the Method
The method chosen for sampling is directly dependent on the sampling site.
The Swab
For collecting samples from surfaces or body openings of humans or animals, swabs are the ideal tool—especially for the subsequent transport of bacteriological and cytological samples.
Swabs are available in various designs and materials, such as a sturdy plastic shaft or a flexible aluminium shaft, depending on the application site. Additionally, there are versions with and without transport medium. For longer transport routes or particularly sensitive microorganisms, it is advisable to choose a swab with a transport medium to stabilise the sample. In some variants, the addition of charcoal in the transport medium serves to neutralise bacterial toxins and other inhibitory substances.

For Urine and Stool Samples
Hygiene is particularly important when collecting urine and stool samples. For liquid samples like urine, the needle-free aspiration method is recommended, allowing the required amount to be drawn from a collection container. This is the gentlest method for transferring urine to secondary containers, as scientifically proven (Link Delanghe et.al. Paper). An alternative method is the vacuum system, where urine is transferred into a tube using negative pressure.
For stool samples, the faeces tubes have proven effective, which are available in various sizes. The sample is hygienically and easily transferred into the tube using a spoon integrated into the screw cap.
General Containers
In addition to these specially designed products for sample collection and transport, a variety of sterile tubes, cups, and other containers ensure that collected samples reach the research facility or laboratory under ideal conditions.
Cultivating Microorganisms
After collecting the samples, the next step is cultivating the microorganisms. Different techniques and materials are used depending on the subsequent analysis.
The Petri Dish
Petri dishes are a classic tool for cultivating microorganisms They are ideal for working with hot nutrient media for cultivation due to their heat resistance up to 80 °C. They are available in various sizes and versions, please refer to the product catalogue for more informationPetri dishes come with or without venting cams. The cultivation application determines which variant to choose. Petri dishes with venting cams offer improved gas exchange, while those without reduce evaporation rates, allowing for longer incubation times. Some Petri dishes are divided into different sections, enabling parallel investigations under comparable conditions or the use of different agars Furthermore, the petri dishes are easily stackable and can be optimally transported and cultivated in large quantities in the laboratory using dish rack stands.

Product Highlights
Analysis of Cultivated Microorganisms
The aim of the analysis is to verify whether a specific microorganism is present at the sampling site and to quantify how many are present. Often, the presence of microorganisms up to a defined limit is considered uncritical and only above that is deemed critical or health-threatening.
Various methods, such as photometric or microscopic examinations, are used depending on the question. Techniques such as immunoassays—like enzyme-linked immunosorbent assays (ELISAs)—and polymerase chain reactions (PCRs) are also employed.

Product Highlights
Disposal of Contaminated Materials
After cultivating and analysing the samples, they are usually no longer needed and disposed of—however, this requires protocols to be followed.
Biological substances are classified into four categories according to EU guidelines, with group 1 being low risk biological substances and group 4 posing a higher risk of infection. . Therefore biological waste is collected in autoclave bags, which SARSTEDT have available in different sizes. These bags must be labelled according to the respective hazard classification level, such as with the "Biohazard" symbol. Before disposal, the biological waste bag must be sterilised using the autoclave therefore the bag must withstand high temperatures—usually up to 134 °C

Sample Archiving
In addition to the analysis performed, it is often necessary to archive samples or store them for later repetition. A well-known example is the collection of microorganisms at the Leibniz Institute DSMZ—German Collection of Microorganisms and Cell Cultures, where researchers have discovered new antibiotic-producing properties in a bacterium that has been studied for over 40 years, thanks to new technologies.Sample archiving sometimes also has legal reasons, for example, in the food industry, where a reference sample must always be retained for products containing raw chicken egg ingredients.
The Right Containers for Archiving
For sample archiving, containers must meet special requirements, such as being suitable for sub-zero storage temperatures or durable to ensure research success even after 40 years or more. Test tubes, micro screw tubes, deep well plates, and cryo vials are used, fulfilling various storage requirements.

Care and Cleanliness
Care and cleanliness are paramount for all microbiological work to achieve meaningful, unaltered, and reliable results.Sterile products are essential for this purpose.
For some analysis—such as working with nucleic acids within PCR techniques—additional material requirements must be met.
Life is not always science.
But science is our Life.
At SARSTEDT, our work follows the principle: Impress with quality, retain with service. Reliability and experience, innovation and dynamism – we build on proven and reliable values, combined with active processes and partnership-based thinking and action.
